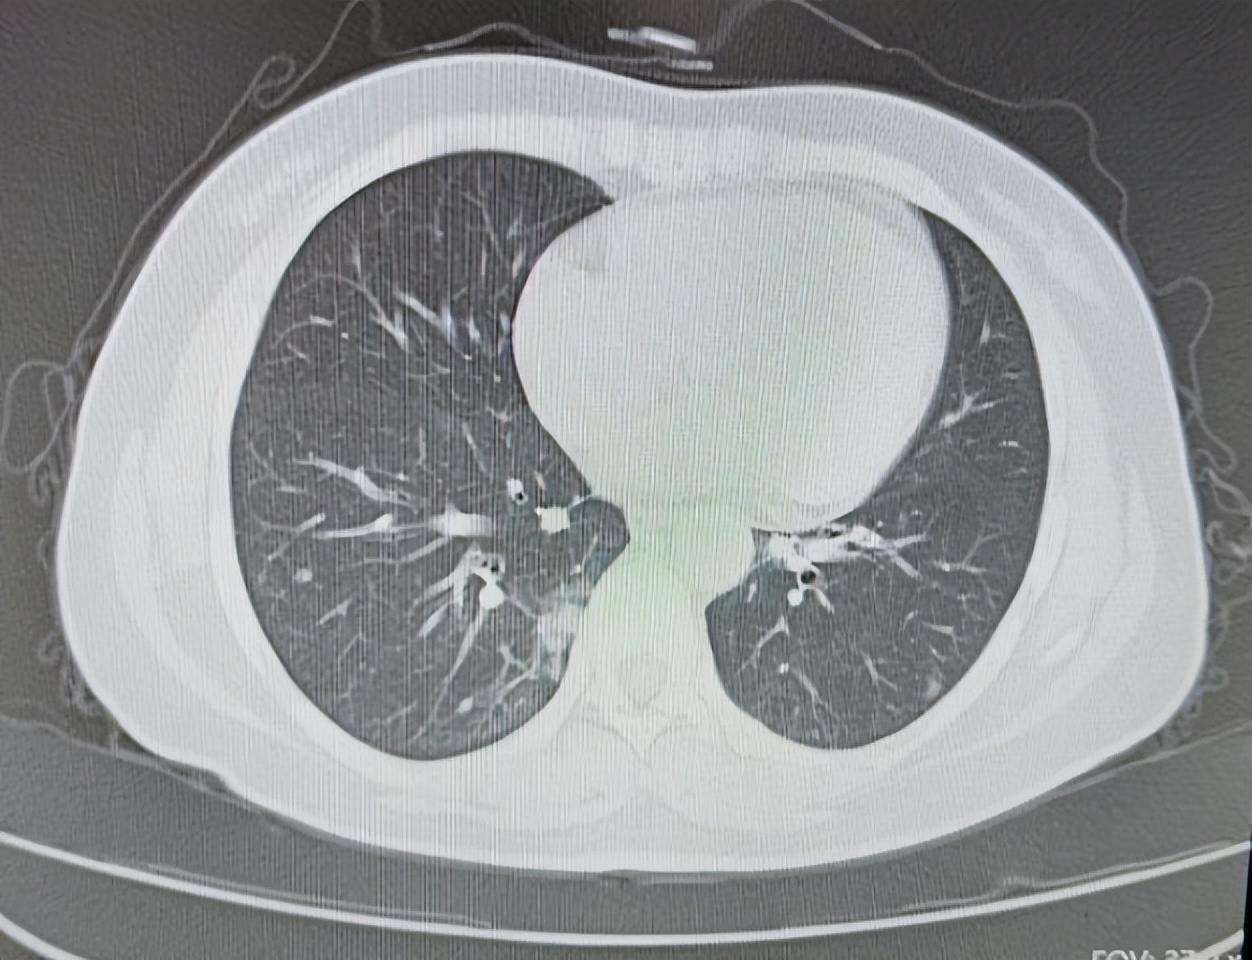
60岁大叔咳嗽不止疑似肺癌,李大爷治咳嗽方法

*声明:本文仅用于科普用途,不能作为治疗依据,为了保护患者隐私,以下内容里的相关信息已进行处理

转自小荷健康App真实经验
【基本信息】男
【疾病类型】肺腺癌
【治疗方案】培美曲塞联合顺铂的化疗方案
【治疗周期】6个周期
【治疗效果】病情稳定
初识患者
大爷姓李,2018年底无明显诱因出现间断咳嗽咳痰,受凉后加重,在我们医院诊断为慢性阻塞性肺病肺气肿慢性支气管炎,对症治疗后有所好转,其后定期复查,2019年6月在医院做胸部CT检查发现右肺有阴影。PET- CT检查提示,双肺多发结节及类结节影,部分结节葡萄糖代谢增高,考虑结核等肉芽肿性病变。
当时患者没在意,后来又在我们医院做胸部增强CT提示,右肺下叶背段占位考虑恶性,建议穿刺,纵隔及右肺门区多发肿大,淋巴结考虑转移可能性大。
2020年1月,在CT引导下,肺主穿刺活检病理提示肺组织中可见肿瘤细胞呈巢团状排列,细胞有异型性,考虑为 肺腺癌 。
知道得了肺癌,大爷从呼吸科转到肿瘤科挂了我的号,第一次来门诊乐呵呵地走进来,给我放了一袋子糖,说怕我看病人多,顾不上吃饭,含块儿糖别低血糖。
图片来源 :讲述者提供
患者的治疗过程
我耐心地给大爷和家属讲解着肺癌的情况和分期,大爷罹患的是 非小细胞肺癌中的腺癌 ,已经有双肺及纵隔淋巴结转移,所以分期为四期。
庆幸的是目前还没有其他脏器的转移,但是大爷的肺功能不好,有慢阻肺和肺气肿,所以在化疗的时候还需要严密监测肺功能,同时治疗慢阻肺和肺气肿的药物不能停,建议患者做一个 EGFR靶标检测 ,看看后期是否能应用口服的靶向药物或者静脉抗血管生成的药物来控制病情。
在医生,患者,家属的共同协商后,最后给大爷选择了耐受性较好,副作用较小的 培美曲塞联合顺铂的化疗方案 ,这个方案对于晚期一线老年患者耐受性更好一些,恶心呕吐骨髓抑制的发生率较其他方案组合要低一些,医生的使用经验比较多,但是由于患者本身基础病较多,尤其是肺功能不佳,所以使用过程中可能还会出现因为不耐受而中断治疗的情况。
因此医生决定先实施两个周期的化疗,评定一下治疗效果以及患者身体情况是否可以继续,如果情况如我们所预期一样,后面继续再进行四个周期化疗,同时经过呼吸科大夫的会诊,加用噻托溴铵粉吸入剂治疗慢阻肺和肺气肿,这样能够更好的保护患者肺功能,减少化疗中造成的不适对肺部造成的压力。
患者在治疗中的注意事项
1.化疗过程中,患者多数会出现骨髓抑制,恶心呕吐肝肾损伤等症状,化疗结束后多半可以缓解,严重的不良反应需要对症治疗。
2.化疗会出现食欲减退,体重减轻,应该积极配合止吐治疗,尽可能保证营养,确保治疗顺利完成。
3.虽然患者没有吸烟史,但是肺功能差,同时还合并高血压糖尿病等疾病,除按时进行抗肿瘤治疗外,还应该积极治疗基础病,按时服药。
患者的治疗效果
虽然不幸罹患的肺癌,但是大爷总是保持着一种积极治疗的心态,经过6个周期的化疗,检测EGFR基因为突变状态,口服靶向药物厄洛替尼进入维持治疗阶段,肿瘤虽然没有完全消失,患者也出现了较为严重的皮疹,但是肿瘤并没有进一步发展,临床上可以判断为疾病稳定。
患者在日常生活中的注意事项
1.患者肺功能较差,同时合并其他基础病, 在空气污染时,应该绝对禁止户外活动 ,同时注意保暖,防止感冒和呼吸道感染,适当进行身体锻炼,以慢走,太极类为宜。
2. 饮食上应该以蒸煮为主,减少或避免吸入炒菜油烟 ,多食用蔬菜,合并糖尿病患者应适度食用水果。避免油炸,辛辣刺激食物。
医生感悟
大爷是我遇到的病人里,为数不多的,从来不把自己当肿瘤晚期病人的患者,每次都是笑呵呵来,笑呵呵走,每次都像是到诊室来给我送点吃的的亲人,从外表看不出他是一个肺癌患者,这为他的治疗,打下了一定的心理基础。
在肿瘤科这么多年,绝大多数年龄大于50岁的患者,都或多或少不单单是肿瘤这一种疾病,合并单一或多种合并症的患者很多,因此肿瘤也不光是一个独立治疗的疾病,有相对好的身体基础,是抗肿瘤的关键因素,这就需要多科室合作到同一个病人身上,哪有问题对症治哪里,有的放矢。
大爷有高血压糖尿病等基础病,在化疗过程中,进行过两次调整降压降糖药治疗,肺功能差,呼吸科进行过几次会诊调整药物,目的都是为治疗肿瘤保驾护航。
每一个科室的医生都使出浑身解数,按照疾病的紧急顺序,为患者提供最适合最舒适的治疗,所以每当一位患者病情得到了控制,都是大家通力合作的结果,当然还有病人给予的信任。
肿瘤兄,不好意思了,这一阶段,我们胜利了!
著作权归作者史铭所有
*声明:本文仅用于科普用途,不能作为治疗依据,为保护患者隐私,文章里的相关信息已进行处理。真实经验是作者本人或家人的真实治疗经验,版权归作者所有,禁止转载。如您发现内容有误,欢迎在留言区或后台进行反馈。
想了解更多肺癌相关真实经验案例?推荐阅读↓↓↓
- 《老骥伏枥,76岁上“战场”抗击肺癌,单孔胸腔镜歼灭原位癌》点击「链接」立即阅读>>
- 《患肺癌3年我学会了如何提免疫力,远离癌症你要做到这几点》点击「链接」立即阅读>>
- 《患上肺癌后,我通过睡眠提高免疫力》点击「链接」立即阅读>>